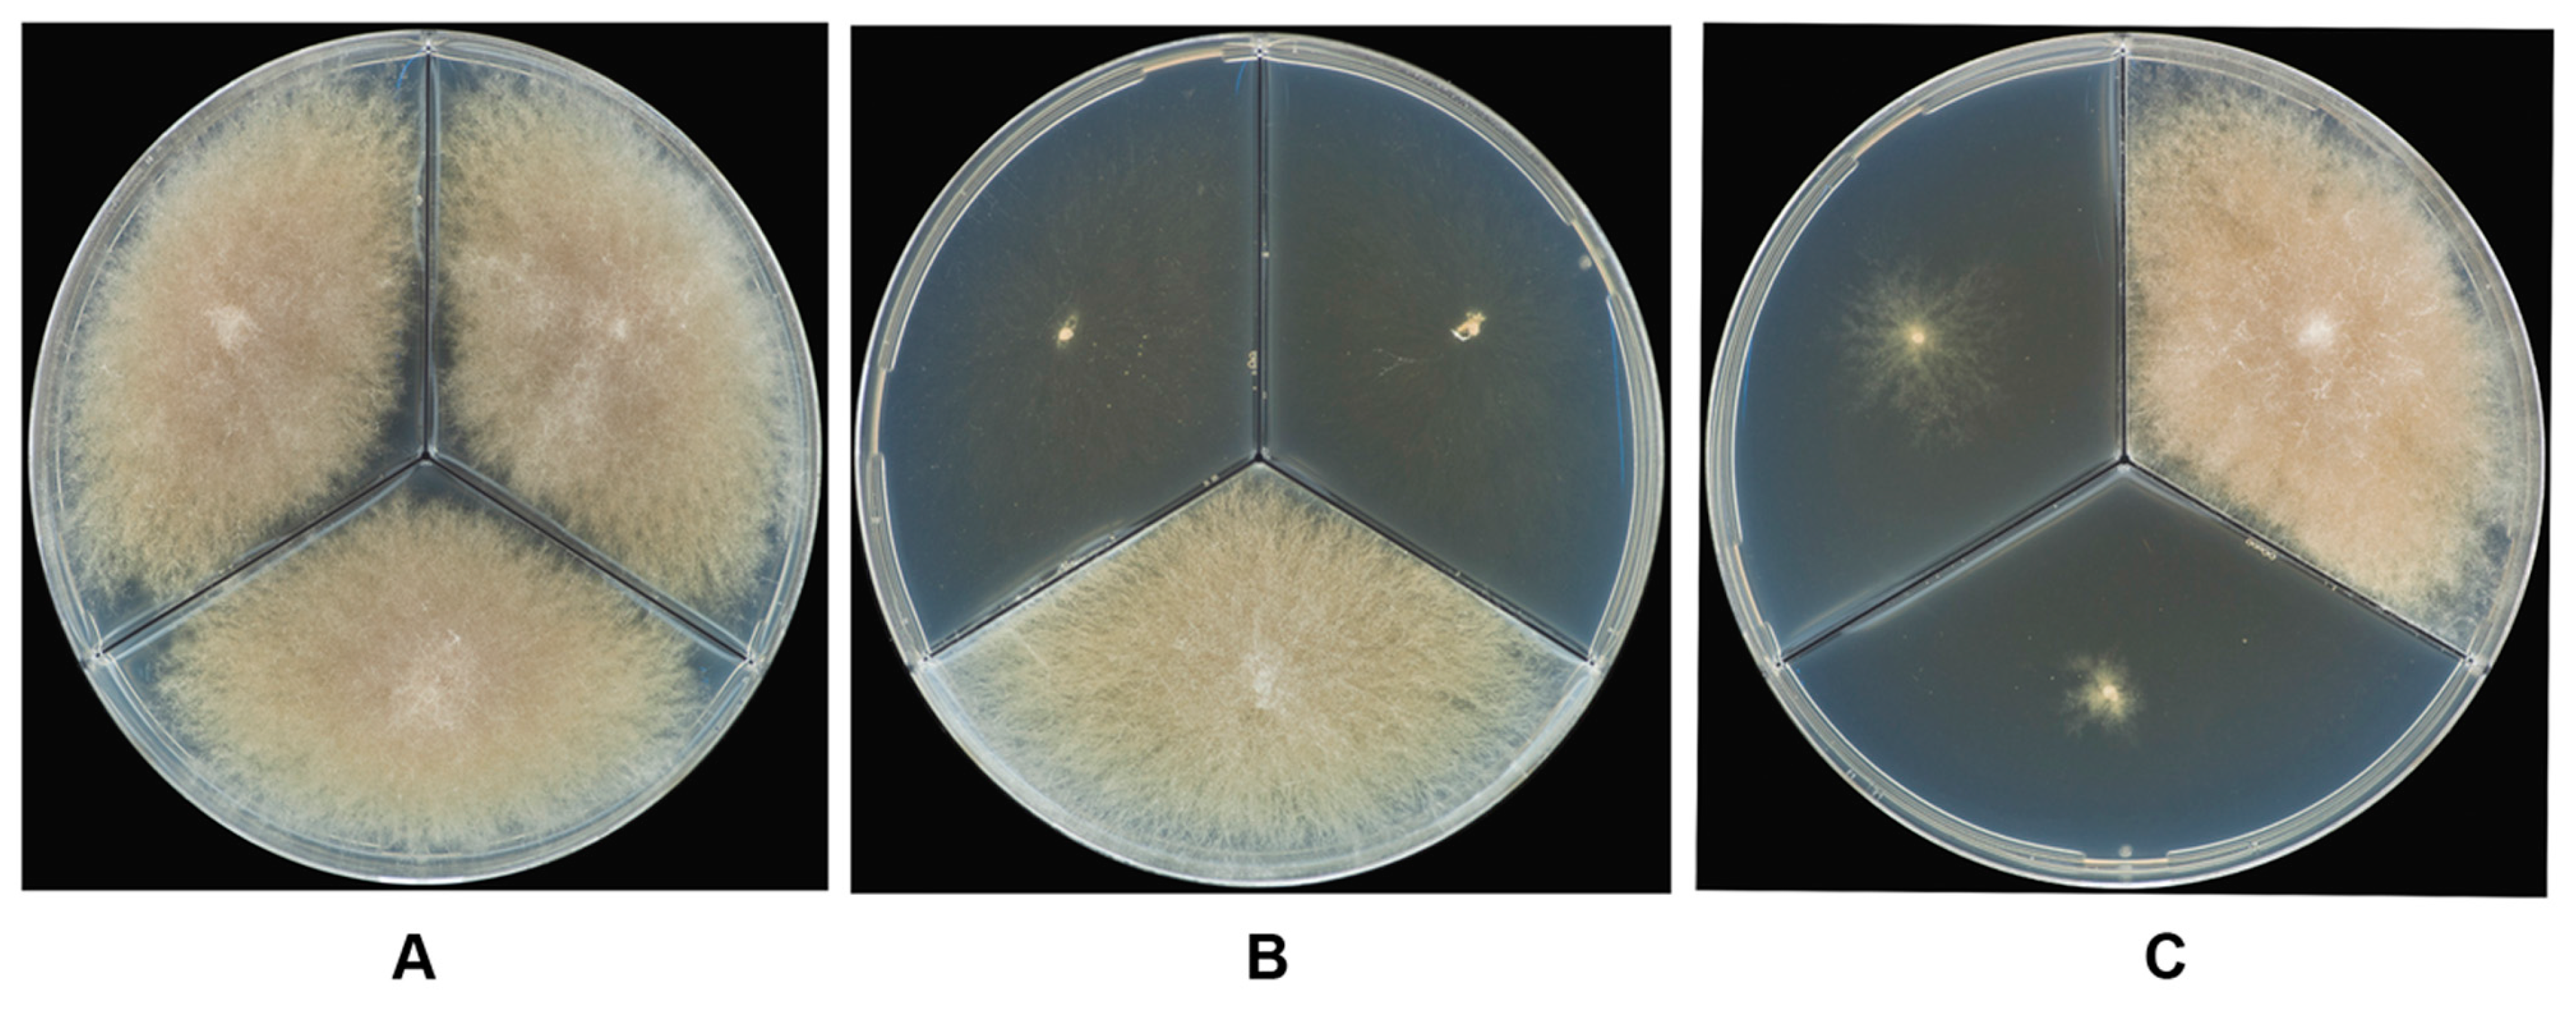
Microorganisms 05 00014 g004 550

Identification and Characterization of Spontaneous Auxotrophic Mutants in Fusarium langsethiae
Abstract
:1. Introduction
2. Materials and Methods
2.1. Fungal Strains
2.2. DNA Isolation and PCR Amplification
2.3. Culture Media for Fungi Growth
2.4. Morphological Studies
2.5. Mycotoxin Analysis
2.6. Identification of Auxotrophic Mutants
2.7. Statistical Analysis
3. Results
3.1. PCR Amplification
3.2. Morphological Studies
3.3. The Growth Rate of Strains at Different Temperatures and Media
3.4. The Toxin Production Ability of Strains Grown on Different Media
3.5. Identification of Auxotrophic Mutants
4. Discussion
Acknowledgments
Author Contributions
Conflicts of Interest
References
- Torp, M.; Nirenberg, H.I. Fusarium langsethiae sp. nov. on cereals in Europe. Int. J. Food Microbiol. 2004, 95, 247–256. [Google Scholar] [CrossRef] [PubMed]
- Knutsen, A.K.; Torp, M.; Holst-Jensen, A. Phylogenetic analyses of the Fusarium poae, Fusarium sporotrichioides and Fusarium langsethiae species complex based on partial sequences of the translation elongation factor-1 alpha gene. Int. J. Food Microbiol. 2004, 95, 287–295. [Google Scholar] [CrossRef] [PubMed]
- Konstantinova, P.; Yli-Mattila, T. IGS-RFLP analysis and development of molecular markers for identification of F. poae, F. langsethiae, F. sporotrichioides and F. kyushuense. Int. J. Food Microbiol. 2004, 95, 321–331. [Google Scholar] [CrossRef] [PubMed]
- Yli-Mattila, T.; Mach, R.; Alekhina, I.A.; Bulat, S.A.; Koskinen, S.; Kullnig-Gradinger, C.M.; Kubicek, C.P.; Klemsdal, S.S. Phylogenetic relationship of Fusarium langsethiae to Fusarium poae and F. sporotrichioides as inferred by IGS, ITS, β-tubulin sequence and UP-PCR hybridization analysis. Int. J. Food Microbiol. 2004, 95, 267–285. [Google Scholar] [CrossRef] [PubMed]
- Yli-Mattila, T.; Ward, T.; O’Donnell, K.; Proctor, R.H.; Burkin, A.; Kononenko, G.; Gavrilova, O.; Aoki, T.; McCormick, S.P.; Gagkaeva, T. F. sibiricum sp. nov; a novel type A trichothecene-producing Fusarium from northern Asia closely related to F. sporotrichioides and F. langsethiae. Int. J. Food Microbiol. 2011, 147, 58–68. [Google Scholar] [CrossRef] [PubMed]
- Bocarov-Stancic, A.; Levic, J.; Stankovic, S.; Tancic, S.; Krnjaja, V.; Salma, N. Toxigenic potential of Fusarium langsethiae isolates from Serbian wheat kernels. Cereal Res. Commun. 2008, 36, 345–346. [Google Scholar]
- Gagkaeva, T.Y.; Gavrilova, O.; Kononenko, G.; Burkin, A.; Yli-Mattila, T. Distribution, cultural characters and toxin production of F. poae, F. sporotrichioides, and F. langsethiae isolates. In Book of Abstracts of XV Congress of European Mycologists; TREEART LLC: St.-Petersburg, Russia, 2007. [Google Scholar]
- Imathiu, S.M.; Ray, R.V.; Back, M.; Hare, M.C.; Edwards, S.G. Fusarium langsethiae pathogenicity and aggressiveness towards oats and wheat in wounded and unwounded in vitro detached leaf assays. Eur. J. Plant Pathol. 2009, 124, 117–126. [Google Scholar] [CrossRef]
- Infantino, A.; Pucci, N.; Conga, G.; Santori, A. First report of Fusarium langsethiae on durum wheat kernels in Italy. Plant Dis. 2007, 91, 1362. [Google Scholar] [CrossRef]
- Lukanowski, A.; Sadowsky, C. Fusarium langsethiae on kernels of winter wheat in Poland—Occurrence and mycotoxigenic abilities. Cereal Res. Commun. 2008, 36, 453–457. [Google Scholar] [CrossRef]
- Torp, M.; Adler, A. The European Sporotrichiella Project: A polyphasic approach to the biology of new Fusarium species. Int. J. Food Microbiol. 2004, 95, 257–266. [Google Scholar] [CrossRef] [PubMed]
- Treikale, O.; Javoisha, B.; Feodorova-Fedotova, L.; Grantina-Ievina, L.; Volkova, J. Occurrence of Fusarium species on small cereals in Latvia. Commun. Agric. Appl. Biol. Sci. 2015, 80, 551–554. [Google Scholar] [PubMed]
- Thrane, U.; Adler, A.; Clasen, P.E.; Galvano, F.; Langseth, W.; Logrieco, A.; Nielsen, K.F.; Ritieni, A. Diversity in metabolite production by Fusarium langsethiae, Fusarium poae, and Fusarium sporotrichioides. Int. J. Food Microbiol. 2004, 95, 257–266. [Google Scholar] [CrossRef] [PubMed]
- Divon, H.H.; Razzaghian, J.; Udnes-Aamot, H.; Klemsdal, S.S. Fusarium langsethiae (Torp and Nirenberg), investigation of alternative infection routes in oats. Eur. J. Plant Pathol. 2012, 132, 147–161. [Google Scholar] [CrossRef]
- Hofgaard, I.S.; Seehusen, T.; Aamot, H.U.; Riley, H.; Razzaghian, J.; Le, V.H.; Hjelkrem, A.G.; Dill-Macky, R.; Brodal, G. Inoculum potential of Fusarium spp. relates to tillage and straw management in Norwegian fields of spring oats. Front. Microbiol. 2016, 7, 556–571. [Google Scholar] [CrossRef] [PubMed]
- Opoku, N.; Back, M.; Edwards, S.G. Aggressiveness of Fusarium langsethiae isolates towards wheat, barley and oats in an in vitro leaf assay. Plant Breed. Seed Sci. 2011, 64, 55–63. [Google Scholar] [CrossRef]
- Kokkonen, M.; Ojala, L.; Parikka, P.; Jestoi, M. Mycotoxin production of selected Fusarium species at different culture conditions. Int. J. Food Microbiol. 2010, 143, 17–25. [Google Scholar] [CrossRef] [PubMed]
- Medina, A.; Magan, N. Temperature and water activity effects on production of T-2 and HT-2 by Fusarium langsethiae strains from north European countries. Food Microbiol. 2011, 28, 392–398. [Google Scholar] [CrossRef] [PubMed]
- Infantino, A.; Santori, A.; Aureli, G.; Belocchi, A.; De Felice, S.; Tizzani, L.; Lattanzio, V.M.T.; Haidukowski, M.; Pascale, M. Occurrence of Fusarium langsethiae strains isolated from durum wheat in Italy. J. Phytopathol. 2015, 163, 612–619. [Google Scholar] [CrossRef]
- Mateo, E.M.; Valle-Algarra, F.M.; Mateo, R.; Jiménez, M.; Magan, N. Effect of fenpropimorph, prochloraz and tebuconazole on growth and production of T-2 and HT-2 toxins by Fusarium langsethiae in oat-based medium. Int. J. Food Microbiol. 2011, 151, 289–298. [Google Scholar] [CrossRef] [PubMed]
- Medina, A.; Magan, N. Comparisons of water activity and temperature impacts on growth of Fusarium langsethiae strains from northern Europe on oat-based media. Int. J. Food Microbiol. 2010, 142, 365–369. [Google Scholar] [CrossRef] [PubMed]
- Mylona, K.; Magan, N. Fusarium langsethiae: Storage environment influences dry matter losses and T2 and HT-2 toxin contamination of oats. J. Stored Prod. Res. 2011, 47, 321–327. [Google Scholar] [CrossRef]
- Nazari, L.; Pattori, E.; Terzi, V.; Morcia, C.; Rossi, V. Influence of temperature on infection, growth, and mycotoxin production by Fusarium langsethiae and F. sporotrichioides in durum wheat. Food Microbiol. 2014, 39, 19–26. [Google Scholar] [CrossRef] [PubMed]
- Nazari, L.; Manstretta, V.; Rossi, V. A non-linear model for temperature-dependent sporulation and T-2 and HT-2 production of Fusarium langsethiae and Fusarium sporotrichioides. Fungal Biol. 2016, 120, 562–571. [Google Scholar] [CrossRef] [PubMed]
- Leslie, J.F.; Summerell, B.A. The Fusarium Laboratory Manual; Blackwell Publishing: Hoboken, NJ, USA, 2006. [Google Scholar]
- Gagkaeva, Т.Y.; Gavrilova, О.P. Production of T-2 toxin and diacetoxyscirpenol by Fusarium fungi on different nutrient media. Agric. Chem. 2013, 8, 96–101. (In Russian) [Google Scholar]
- White, T.J.; Bruns, T.; Lee, S.; Taylor, J. Amplification and direct sequencing of fungal ribosomal RNA genes for phylogenetics. In PCR Protocols: A Guide to Methods and Applications; Innis, M.A., Gelfand, D.H., Sninsky, J.J., White, T.J., Eds.; Academic Press: New York, NY, USA, 1990; pp. 315–322. [Google Scholar]
- Samson, R.A.; Hoekstra, E.S.; Frisvad, J.C.; Filtenborg, O. Introduction to Food-and Airborne Fungi, 6th ed.; Centraalbureau voor Schimmelcultures: Utrecht, The Netherlands, 2002. [Google Scholar]
- Nirenberg, H.I. Untersuchungen über die morphologische und biologische Differenzierung in der Fusarium-Section Liseola. Mitt. Biol. Bundesanst. Land-u Forstwirtsch. 1976, 169, 1–117. [Google Scholar]
- Holliday, R. A new method for the identification of biochemical mutants of microorganisms. Nature 1956, 178, 987. [Google Scholar] [CrossRef]
- Omer, Z.; Fatehi, J.; Wallenjammar, A.C. Quick and Reliable Detection of Fusarium langsethiae with “Loop-Mediated Isothermal Amplification” Method; Final Report for Stiftelsen Lantbruksforskning (SLF, Project H1333237): Stockholm, Sweden, 2015. [Google Scholar]
- Gavrilova, О.P.; Gagkaeva, Т.Y. Effect of temperature and tebuconazole on the growth and toxin production of Fusarium langsethiae strains of different geographical origin. Agric. Chem. 2015, 12, 76–82. (In Russian) [Google Scholar]
- Beever, R.E.; Bollard, E.G. The nature of the stimulation of fungal growth by potato extract. Microbiology 1970, 60, 273–279. [Google Scholar] [CrossRef]
- Griffin, D.H. Fungal Physiology, 2nd ed.; John Wiley and Sons: New York, NY, USA, 1996. [Google Scholar]
- Esposito, R.G.; Greenwood, H.; Fletcher, A.M. Growth factor requirements of six fungi associated with fruit decay. J. Bacteriol. 1962, 83, 250–255. [Google Scholar] [PubMed]
- Rodionov, D.A.; Vitreschak, A.G.; Mironov, A.A.; Gelfand, M.S. Comparative genomics of thiamin biosynthesis in procaryotes. New genes and regulatory mechanisms. J. Biol. Chem. 2002, 277, 48949–48959. [Google Scholar] [CrossRef] [PubMed]
- Pirner, H.M.; Stolz, J. Biotin sensing in Saccharomyces cerevisiae is mediated by a conserved DNA element and requires the activity of biotin-protein ligase. J. Biol. Chem. 2006, 281, 12381–12389. [Google Scholar] [CrossRef] [PubMed]
- Satiaputra, J.; Shearwin, K.E.; Booker, G.W.; Polyak, S.W. Mechanisms of biotin-regulated gene expression in microbes. Synth. Syst. Biotechnol. 2016, 1, 17–24. [Google Scholar] [CrossRef]
- Dedeurwaerder, G.; Ghysselinckx, J.; Hellin, P.; Janssen, F.; Duvivier, M.; Legrève, A. Detection of Fusarium langsethiae on wheat in Belgium. Eur. J. Plant Pathol. 2014, 139, 453–455. [Google Scholar] [CrossRef]
- Imathiu, S.M.; Ray, R.V.; Back, M.; Hare, M.; Edwards, S.G. In vitro growth characteristics of Fusarium langsethiae isolates recovered from oats and wheat grain in the UK. Acta Phytopathol. Entomol. Hung. 2016, 51, 159–169. [Google Scholar] [CrossRef]
- Frandsen, R.J.; Nielsen, N.J.; Maolanon, N.; Sørensen, J.C.; Olsson, S.; Nielsen, J.; Giese, H. The biosynthetic pathway for aurofusarin in Fusarium graminearum reveals a close link between the naphthoquinones and naphthopyrones. Mol. Microbiol. 2006, 61, 1069–1080. [Google Scholar] [CrossRef] [PubMed]
- Lysøe, E.; Divon, H.H.; Terzi, V.; Orru, L.; Lamontanara, A.; Kolseth, A.K.; Frandsen, R.J.; Nielsen, K.; Thrane, U. The draft genome sequence of Fusarium langsethiae, a T-2/HT-2 mycotoxin producer. Int. J. Food Microbiol. 2016, 221, 29–36. [Google Scholar] [CrossRef] [PubMed]
- Fredlund, E.; Gidlund, A.; Pettersson, H.; Olsen, M.; Börjesson, T. Real-time PCR detection of Fusarium species in Swedish oats and correlation to T-2 and HT-2 toxin content. World Mycotoxin J. 2010, 3, 77–88. [Google Scholar] [CrossRef]
- Halstensen, A.S.; Nordby, K.C.; Eduard, W.; Klemsdal, S.S. Real-time PCR detection of toxigenic Fusarium in airborne and settled grain dust and associations with trichothecene mycotoxins. J. Environ. Monit. 2006, 8, 1235–1241. [Google Scholar] [CrossRef] [PubMed]
- Imathiu, S.M.; Ray, R.V.; Back, M.A.; Hare, M.C.; Edwards, S.G. A survey investigating the infection of Fusarium langsethiae and production of HT-2 and T-2 mycotoxins in UK oat fields. J. Phytopathol. 2013, 161, 553–561. [Google Scholar] [CrossRef]
- Nicolaisen, M.; Suproniene, S.; Nielsen, L.K.; Lazzaro, I.; Spliid, N.H.; Justesen, A.F. Real-time PCR for quantification of eleven individual Fusarium species in cereals. J. Microbiol. Methods 2009, 76, 234–240. [Google Scholar] [CrossRef] [PubMed]
- Yli-Mattila, T.; Parikka, P.; Lahtinen, T.; Ramo, S.; Kokkonen, M.; Rizzo, A.; Jestoi, M.; Hietaniemi, V. Fusarium DNA levels in Finnish cereal grains. In Current Advances in Molecular Mycology; Gherbawy, Y., Mach, R.L., Rai, M., Eds.; Nova Science Publishers: New York, NY, USA, 2009; pp. 107–138. [Google Scholar]
- Kosiak, B.; Torp, M.; Skjerve, E.; Thrane, U. The prevalence and distribution of Fusarium species in Norwegian cereals: A survey. Acta Agric. Scand. B 2003, 53, 168–176. [Google Scholar]
- Edwards, S.G.; Imathiu, S.; Ray, R.V.; Back, M.; Hare, C.M. Molecular studies to identify the Fusarium species responsible for HT-2 and T-2 mycotoxins in UK oats. Int. J. Food Microbiol. 2012, 156, 168–175. [Google Scholar] [CrossRef] [PubMed]
- Misir, R.; Blair, R. Biotin bioavailability of protein supplements and cereal grains for starting turkey poults. Poult. Sci. 1988, 67, 1274–1280. [Google Scholar] [CrossRef] [PubMed]
- Staggs, C.G.; Sealey, W.M.; McCabe, B.J.; Teague, A.M.; Mock, D.M. Determination of the biotin content of select foods using accurate and sensitive HPLC/avidin binding. J. Food Compos. Anal. 2004, 17, 767–776. [Google Scholar] [CrossRef] [PubMed]
- Koehler, K.R.; Mikosz, A.M.; Molosh, A.I.; Patel, D.; Hashino, E. Generation of inner ear sensory epithelia from pluripotent stem cells in 3D culture. Nature 2013, 500, 217–221. [Google Scholar] [CrossRef] [PubMed]
- Edwards, S.G.; Barrier-Guillot, B.; Clasen, P.E.; Hietaniemi, V.; Pettersson, H. Emerging issues of HT and T-2 toxins in European cereal production. World Mycotoxin J. 2009, 2, 173–179. [Google Scholar] [CrossRef]
- Hofgaard, I.S.; Aamot, H.U.; Torp, T.; Jestoi, M.; Lattanzio, V.M.T.; Klemsdal, S.S.; Waalwijk, C.; van der Lee, T.; Brodal, G. Associations between Fusarium species and mycotoxins in oats and spring wheat from farmers’ fields in Norway over a six-year period. World Mycotoxin J. 2016, 9, 365–378. [Google Scholar] [CrossRef]
- Gardiner, D.M.; Kazan, K.; Manners, J.M. Nutrient profiling reveals potent inducers of trichothecene biosynthesis in Fusarium graminearum. Fungal Genet. Biol. 2009, 46, 604–613. [Google Scholar] [CrossRef] [PubMed]
- Jestoi, M.; Paavanen-Huhtala, S.; Parikka, P.; Yli-Mattila, T. In vitro and in vivo mycotoxin production of Fusarium species isolated from Finnish grains. Arch. Phytopathol. Plant Prot. 2008, 41, 545–558. [Google Scholar] [CrossRef]
- Jiao, F.; Kawakami, A.; Nakajima, T. Effects of different carbon sources on trichothecene production and Tri gene expression by Fusarium graminearum in liquid culture. FEMS Microbiol. Lett. 2008, 285, 212–219. [Google Scholar] [CrossRef] [PubMed]
- Kokkonen, M.; Jestoi, M.; Laitila, A. Mycotoxin production of Fusarium langsethiae and Fusarium sporotrichioides on cereal-based substrates. Mycotoxin Res. 2012, 28, 25–35. [Google Scholar] [CrossRef] [PubMed]
- Mateo, J.J.; Mateo, R.; Jimenez, M. Accumulation of type A trichothecenes in maize, wheat and rice by Fusarium sporotrichioides isolates under diverse culture conditions. Int. J. Food Microbiol. 2002, 72, 115–123. [Google Scholar] [CrossRef]
- Lattanzio, V.M.; Ciasca, B.; Haidukowski, M.; Infantino, A.; Visconti, A.; Pascale, M. Mycotoxin profile of Fusarium langsethiae isolated from wheat in Italy: Production of type-A trichothecenes and relevant glucosyl derivatives. J. Mass Spectrom. 2013, 48, 1291–1298. [Google Scholar] [CrossRef] [PubMed]
- Tolaymat, N.; Mock, D.M. Biotin analysis of commercial vitamin and other nutritional supplements. J. Nutr. 1989, 119, 1357–1360. [Google Scholar] [PubMed]

| No. | VIZR Collection No. | No. in Other Collections/GenBank Accession No. | Year of Isolation | Geographic Origin (Country, Region) | Source | Growth on Basal Czapek (CZ) ** | Intergenic spacer (IGS)-Subgroup |
|---|---|---|---|---|---|---|---|
| 1 * | MFG 203401 | — | 2013 | Russia, Leningrad | oat | + | I |
| 2 * | MFG 11103 | — | 2014 | Russia, Leningrad | triticale | − | II |
| 3 * | MFG 217011 | — | 2014 | Russia, Leningrad | oat | + | I |
| 4 * | MFG 217012 | — | 2014 | Russia, Leningrad | oat | + | I |
| 5 * | MFG 217701 | — | 2014 | Russia, Leningrad | oat | + | I |
| 6 * | MFG 217702 | — | 2014 | Russia, Leningrad | oat | − | II |
| 7 | MFG 133601 | — | 2010 | Russia, Leningrad | oat | − | II |
| 8 | MFG 93001 | — | 2008 | Russia, Leningrad | barley | − | II |
| 9 | MFG 11020 | NRRL 53437/HM060290 | 2008 | Russia, Pskov | oat | + | I |
| 10 | MFG 217903 | — | 2014 | Russia, Pskov | oat | + | I |
| 11 * | MFG 220102 | — | 2014 | Russia, Vologda | oat | + | I |
| 12 * | MFG 223301 | — | 2014 | Russia, Vologda | oat | − | II |
| 13 * | MFG 223302 | — | 2014 | Russia, Vologda | oat | − | II |
| 14 | MFG 223401 | — | 2014 | Russia, Vologda | oat | + | I |
| 15 * | MFG 223402 | — | 2014 | Russia, Vologda | oat | − | II |
| 16 | MFG 224306 | — | 2014 | Russia, Vologda | oat | − | II |
| 17 | MFG 220101 | — | 2014 | Russia, Vologda | oat | + | II |
| 18 | MFG 100601 | — | 2008 | Russia, Vologda | oat | − | II |
| 19 | MFG 100602 | — | 2008 | Russia, Vologda | oat | − | II |
| 20 | MFG 223407 | — | 2014 | Russia, Vologda | oat | − | II |
| 21 | MFG 225401 | — | 2014 | Russia, Arkhangelsk | oat | − | I |
| 22 | MFG 225402 | — | 2014 | Russia, Arkhangelsk | oat | − | I |
| 23 | MFG 225405 | — | 2014 | Russia, Arkhangelsk | oat | − | I |
| 24 | MFG 225406 | — | 2014 | Russia, Arkhangelsk | oat | − | I |
| 25 | MFG 103506 | — | 2008 | Russia, Kaliningrad | oat | + | I |
| 26 | MFG 103507 | — | 2008 | Russia, Kaliningrad | oat | + | I |
| 27 | MFG 11021 | NRRL 53538 | 2008 | Russia, Kaliningrad | oat | + | I |
| 28 | MFG 55201 | — | 2005 | Russia, Kaliningrad | oat | − | II |
| 29 * | — | FI 2004/57 | 2004 | The UK | oat | − | II |
| 30 * | MFG 11037 | FI 062/1 | — | The UK | oat | − | II |
| 31 * | — | FI 026/1 | — | The UK | oat | − | II |
| 32 | — | 9822–219–1F | — | Norway, Østfold | oat | − | II |
| 33 | — | 54–Fin 03 | 2003 | Finland | — | − | II |
| 34 | — | 52–Fin 03 | 2003 | Finland | — | + | I |
| 35 * | MFG 11027 | NRRL 53409/HM060272 | 2003 | Finland, Etelä-Karjala | barley | + | I |
| 36 | MFG 11028 | NRRL 53419/HM060288 | 2003 | Finland, Satakunta | oat | + | I |
| 37 | MFG 11030 | NRRL 53411/HM060282 | 2003 | Finland, Satakunta | oat | + | I |
| 38 | MFG 11029 | NRRL 53410/HM060286 | 2003 | Finland, Satakunta | oat | − | II |
| 39 * | MFG 11033 | NRRL 53414/HM060285 | 2003 | Finland, Häme | wheat | + | I |
| 40 * | MFG 11032 | NRRL 53413/HM060284 | 2003 | Finland, Uusimaa | wheat | + | II |
| 41 * | MFG 11031 | NRRL 53412/HM060283 | 2003 | Finland, Uusimaa | wheat | − | II |
| 42 | MFG 11034 | NRRL 53417/HM060287 | 2003 | Finland, Uusimaa | oat | + | I |
| 43 * | MFG 11035 | NRRL 53418/HM060273 | 2003 | Finland, Etelä-Pohjanmaa | wheat | + | I |
| 44 | MFG 11110 | JF-2015/01 | 2015 | Sweden | oat | − | II |
| 45 | MFG 11111 | JF-2015/14 | 2015 | Sweden | oat | − | II |
| 46 | MFG 11112 | JF-2015/02 | 2015 | Sweden | oat | + | I |
| 47 | MFG 11113 | JF-2015/30 | 2015 | Sweden | oat | − | II |
| 48 | MFG 11114 | JF-2015/32 | 2015 | Sweden | oat | + | II |
| 49 | MFG 232405 | — | 2016 | Latvia | oat | − | II |
| Subgroup | No. of Strains | Growth on PSA at 30 °C | Growth on CZ at 24 °C | Mycotoxins Production on CZ | Phenotype/Nutritional Requirement |
|---|---|---|---|---|---|
| I | 19 | + | + | high | prototroph |
| 4 * | + | − | low | auxotroph for thiamin | |
| II | 24 | − | − | low | auxotroph for biotin |
| 2 ** | − | + | high | prototroph |
© 2017 by the authors. Licensee MDPI, Basel, Switzerland. This article is an open access article distributed under the terms and conditions of the Creative Commons Attribution (CC BY) license (http://creativecommons.org/licenses/by/4.0/).
Share and Cite
Gavrilova, O.; Skritnika, A.; Gagkaeva, T. Identification and Characterization of Spontaneous Auxotrophic Mutants in Fusarium langsethiae. Microorganisms 2017, 5, 14. https://doi.org/10.3390/microorganisms5020014
Gavrilova O, Skritnika A, Gagkaeva T. Identification and Characterization of Spontaneous Auxotrophic Mutants in Fusarium langsethiae. Microorganisms. 2017; 5(2):14. https://doi.org/10.3390/microorganisms5020014
Chicago/Turabian StyleGavrilova, Olga, Anna Skritnika, and Tatiana Gagkaeva. 2017. "Identification and Characterization of Spontaneous Auxotrophic Mutants in Fusarium langsethiae" Microorganisms 5, no. 2: 14. https://doi.org/10.3390/microorganisms5020014
APA StyleGavrilova, O., Skritnika, A., & Gagkaeva, T. (2017). Identification and Characterization of Spontaneous Auxotrophic Mutants in Fusarium langsethiae. Microorganisms, 5(2), 14. https://doi.org/10.3390/microorganisms5020014

